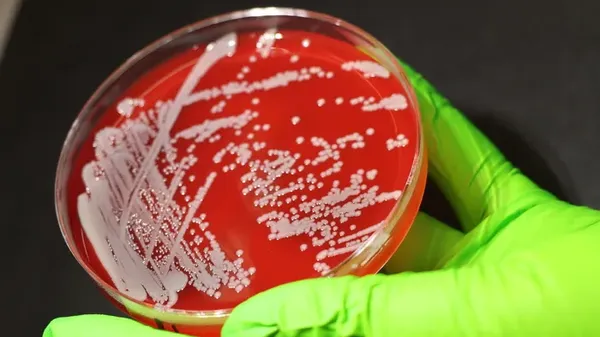

Un fenomeno ai limiti della fisica apre a nuove tecnologie solari
Un fenomeno che sfida i limiti della fisica potrebbe aprire la strada a nuove tecnologie più efficienti per l'energia solare , come pannelli fotovoltaici e dispositivi che producono combustibile a idrogeno . Un gruppo guidato dall'Università di Cambridge, del quale …